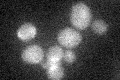
YNL288W
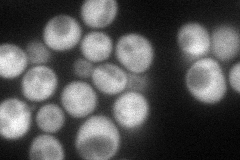
YNL288W
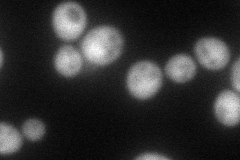
YNL288W
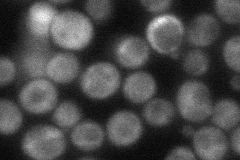
YNL288W
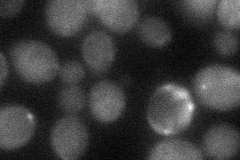
YNL288W
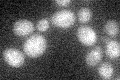
YNL288W

View description
Evolutionarily conserved subunit of the CCR4-NOT complex involved in controlling mRNA initiation, elongation and degradation; binds Cdc39p
Localization:
Intensity:
Fold change:
Significance:
-
C’ GFP library in SD
below threshold15.82 -
N' NOP1pr-GFP in SD
cytosol80.4921 -
N' TEF2pr-mCherry in SD
cytosol77.2368 -
N' NATIVEpr-GFP in SD
cytosol48.8736 -
N' TEF2pr-VC and Cyto-VN in SD
cytosol34.8392 -
C’ GFP library in SD+DTT

cytosol15.730.99No -
C’ GFP library in SD+H2O2

cytosol16.971.07No -
C’ GFP library in Starvation Media
cytosol23.161.46No -
C’ GFP library on the background of Pup2-DaMP

below threshold -
C’ GFP library on the background of CCT mutant

below threshold15.70860.992533No
